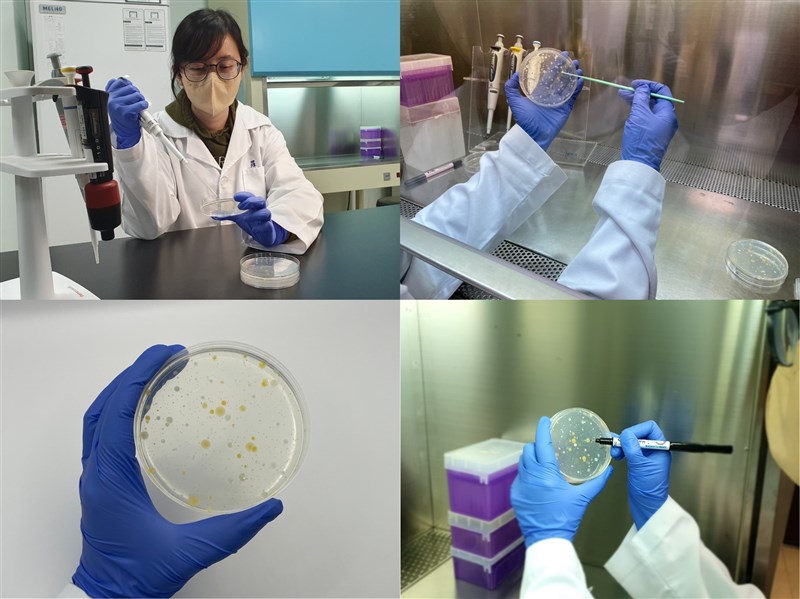

畜試所北區分所牛乳檢驗室人員應用乳微生物檢測技術檢測國產生乳與鮮乳中的微生物含量。圖/畜試所提供
畜試所北區分所牛乳檢驗室人員應用乳微生物檢測技術檢測國產生乳與鮮乳中的微生物含量。圖/畜試所提供
【記者吳亭頤綜合報導】2025年紐西蘭進口液態乳將全面零關稅,農業部畜產試驗所長黃振芳指出,目前已開發出乳微生物檢測技術,獲國內外肯定,可快速檢測15種乳微生物,幫助強化品管。
紐西蘭受國際乳品產業定位為優質乳產地,黃振芳表示,面對2025年紐西蘭進口液態乳全面零關稅,加強國人對於國產乳製品安全性及品質的信任刻不容緩;目前開發出能快速準確檢測15種重要指標之乳微生物檢測技術,相關檢測能力通過國內外能力試驗。
黃振芳提到,畜產所乳品質檢測能力獲得國內及國際一致肯定,更代表守護國內鮮乳品質的能力及決心,希望讓消費者能安心飲用,進而增加購買國產鮮乳的意願。
黃振芳指出,北區分所牛乳檢驗室除每年3月及9月均定期參與國際畜政聯盟(ICAR)乳微生物檢測能力試驗,歷年正確率皆達100%;去年更首次跨足食品領域,參加國內微生物能力試驗機構辦理的「食品微生物領域」總生菌數、大腸桿菌與大腸桿菌群能力試驗,亦獲得滿意評價。
黃振芳表示,乳微生物檢測技術可供乳品加工廠應用於例行性品管作業及危害分析重點管制,更有效地控制產品品質,以符合衛生福利部關於乳品微生物的安全標準;歡迎有興趣的業者與該所聯繫,一同守護國產鮮乳品質。
畜試所說明,生乳中可能含有多種微生物,部分微生物可能對人體健康有害,或影響乳品品質和保存期限;而乳微生物檢測技術的用途就在於檢測生乳與鮮乳中的微生物含量,確保其符合衛生標準及國產鮮乳品質。